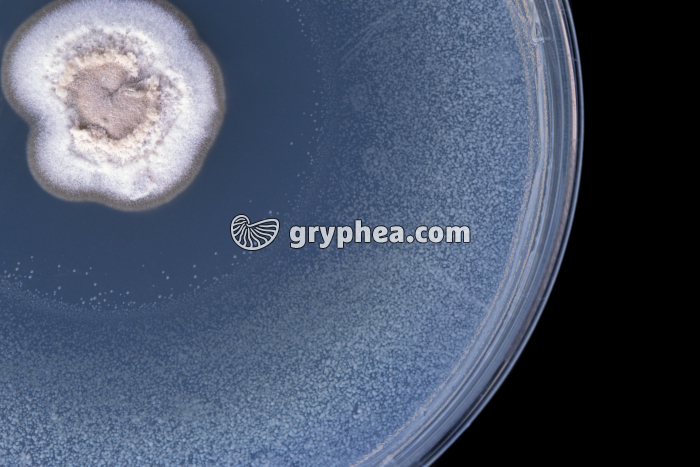
Expérience de Fleming - détail de la culture - découverte du premier antibiotique  - gryphea.org

Les photographies, infographies, vidéos, sons et textes publiés sur ce site ne sont pas totalement libres de droits. Vous pouvez les utiliser librement à titre personnel, dans la création de vos cours, compte-rendus, diaporamas, en respectant le watermark qui y est inclus, à la condition expresse d'avoir souscrit à un abonnement. Le contrat d’utilisation ne vous autorise cependant pas à diffuser ces documents ailleurs que dans le cadre strict de votre enseignement, et en aucun cas sur les réseaux sociaux. Merci de votre compréhension.
Pour accéder à tous les contenus de gryphea.org, aux photos haute définition et aux vidéos intégrales, profitez de nos offres d'abonnement :
En 1928, Fleming, qui rentrait de vacances, découvre une boite de culture de staphylocoques, contaminée par une moisissure bleuâtre. Ce cas, assez courant en microbiologie, aboutit généralement à l'élimination de la culture. Autour de la moisissure, Fleming observe une zone circulaire dépourvue de colonies bactériennes (voir la photo proposée). Au lieu de rejeter cette culture, le chercheur a cherché à comprendre la cause de l'absence de bactéries à proximité du champignon.
Note : l’air qui nous entoure, intérieur comme extérieur, véhicule naturellement des spores de moisissures qui se déposent un peu partout au gré des courants d’air. Lors de l’ensemencement d’une boite de Pétri, il peut arriver qu’une ou plusieurs spores, bactérienne ou fongique, pénètre à l’intérieur et contamine la culture.
Fleming émit ainsi[...]
La suite du commentaire est réservée aux abonnés